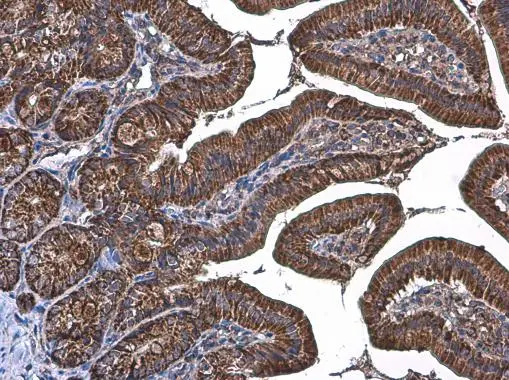

マイストア
変更
お店で受け取る
(送料無料)
配送する
納期目安:
2025.09.18 0:0頃のお届け予定です。
決済方法が、クレジット、代金引換の場合に限ります。その他の決済方法の場合はこちらをご確認ください。
※土・日・祝日の注文の場合や在庫状況によって、商品のお届けにお時間をいただく場合がございます。
K.M.様 Anti-TOMM20 antibody (GTX133756) | GeneTexの詳細情報
Anti-TOMM20 antibody (GTX133756) | GeneTex。BV786 Mouse Anti-Ki-67。2021 Kawasaki ZX636, K | JKBZXJG18MA016069 | BidCars。2019 Kawasaki ZX636, K | JKBZXJH16KA002568 | Bid History。NintendoSwitch同時操作端末 4台用内訳3台用(19000)+追加1台分(3000*1)1台のコントローラーを複数分のコントローラーとして動作させることができるので複数のSwitchに接続すると同時操作を行うことができますボタンやキャプチャボタン、スティック押し込み等の入力にも対応しています動作しているところはYoutubeで「NintendoSwitchを同時操作してみた」というタイトルでアップしてありますウェーブバードを複数用意するより安く同時操作ができます(有線にはなりますが)--同梱物--同時操作用端末
ベストセラーランキングです
近くの売り場の商品
カスタマーレビュー
オススメ度 4.3点
現在、4253件のレビューが投稿されています。